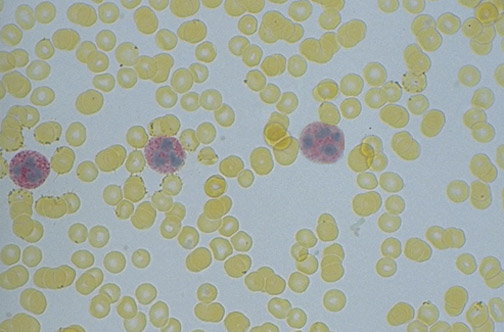

| One way to distinguish a leukemoid reaction from chronic myelogenous leukemia (CML) is with the leukocyte alkaline phosphatase (LAP) stain. Seen here are neutrophils with red cytoplasmic staining for LAP. Counting myeloid cells staining with LAP yields a score. A high LAP score is seen with a leukemoid reaction, while a low LAP score suggests CML. |
![]() |